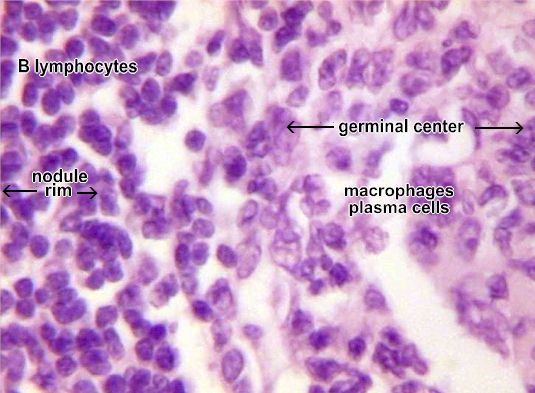

Lymph Node Structure
The capsule is made of collagen and has a subcapsular sinus. The lymph flows into the sinus carrying lymphocytes, antigen processing macrophages and dendritic cells to the node cortex and medulla.
In the cortex are nodules with germinal centers where B lymphocyte mature into plasma cells after activation.
The Medulla in the core of the lymph node mainly processes T - lymphocytes.
The green arrows at the top represent the afferent lymphatic vessels bringing the lymph into the node. Follow the green arrows to the exit of the node at the efferent lymphatic vessel. This arrangement slows the lymph down as it moves through the node.
Click on green squares to see details of the lymph node |
|